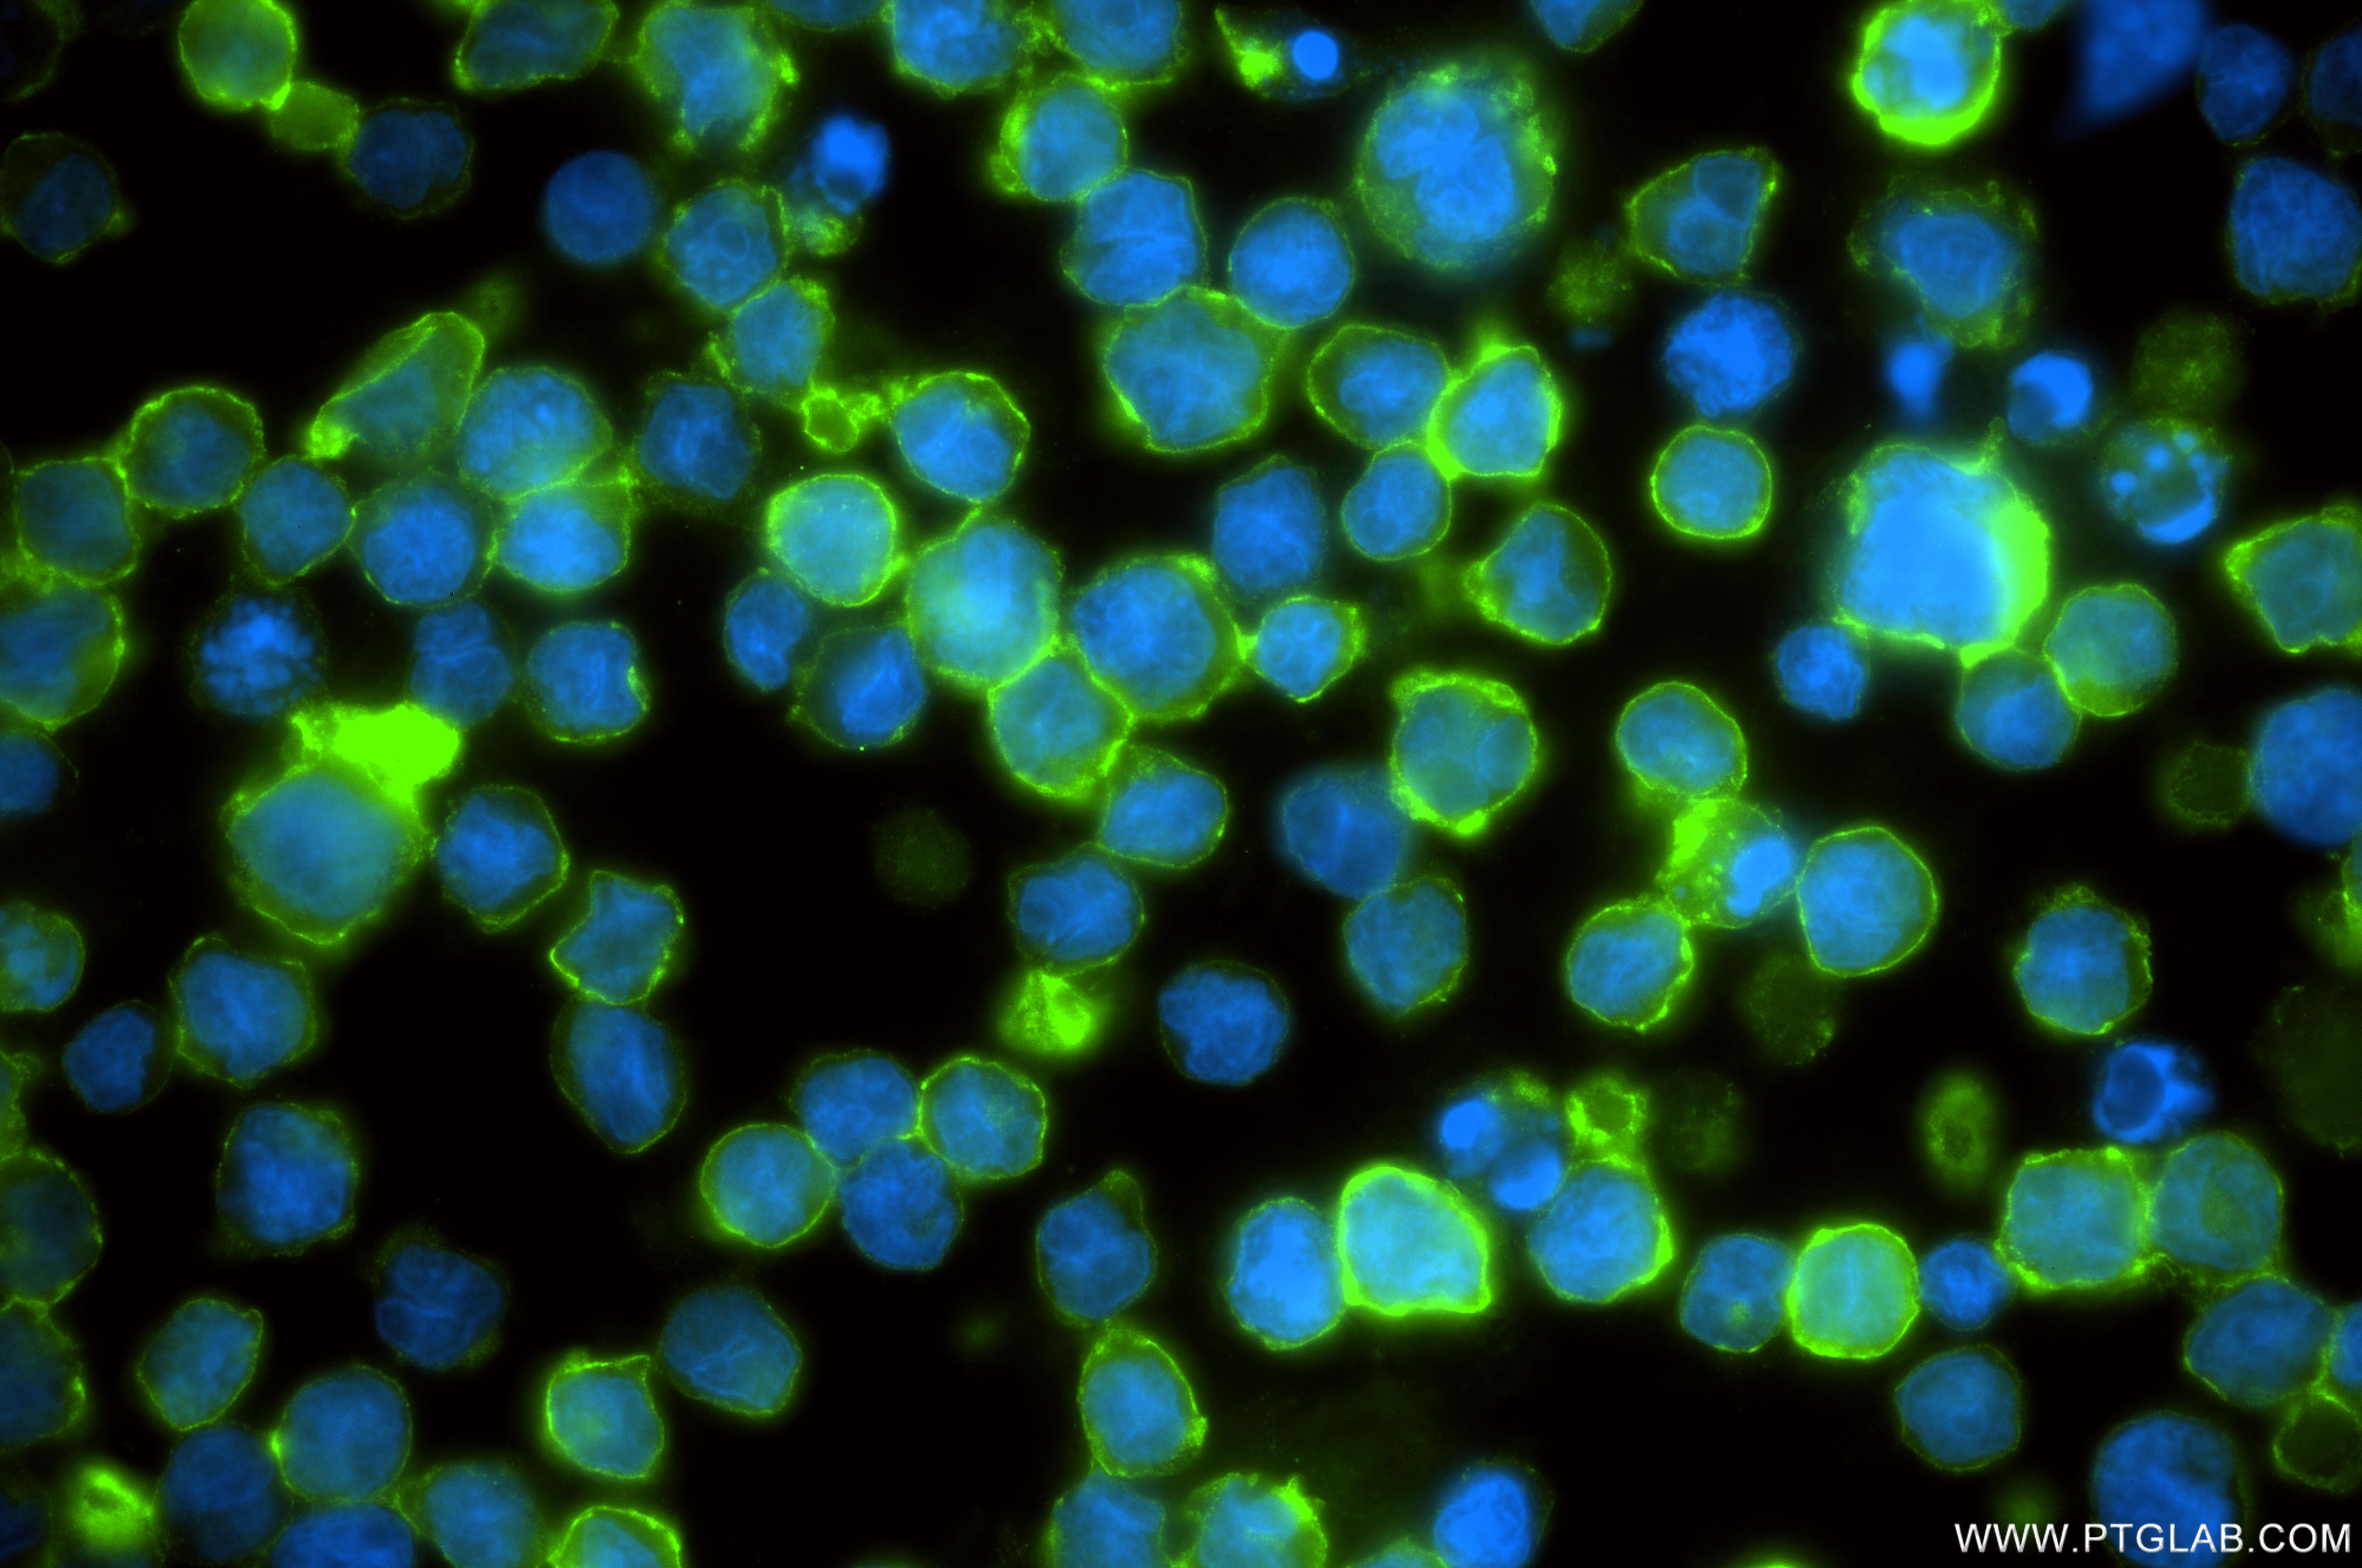
Immunofluorescent analysis of (4% PFA) fixed Raji cells using CD21 antibody (87097-1-RR, Clone: 252181F1 ) at dilution of 1:200 and CoraLite®488-Conjugated Goat Anti-Rabbit IgG(H+L) (SA00013-2). This data was developed using the same antibody clone with 87097-1-PBS in a different storage buffer formulation. Immunofluorescence (IF) / fluorescent staining of Raji cells using CD21 Recombinant monoclonal antibody (87097-1-RR)

Validation Data Gallery
Tested Applications
Recommended dilution
| Application | Dilution |
|---|---|
| It is recommended that this reagent should be titrated in each testing system to obtain optimal results. | |
Product Information
87097-1-PBS targets CD21 as part of a matched antibody pair:
MP02864-2: 87097-3-PBS capture and 87097-1-PBS detection (validated in Sandwich ELISA)
Unconjugated rabbit recombinant monoclonal antibody in PBS only (BSA and azide free) storage buffer at a concentration of 1 mg/mL, ready for conjugation. Created using Proteintech’s proprietary in-house recombinant technology. Recombinant production enables unrivalled batch-to-batch consistency, easy scale-up, and future security of supply.
This conjugation ready format makes antibodies ideal for use in many applications including: ELISAs, multiplex assays requiring matched pairs, mass cytometry, and multiplex imaging applications.Antibody use should be optimized by the end user for each application and assay.
| Tested Reactivity | human |
| Host / Isotype | Rabbit / IgG |
| Class | Recombinant |
| Type | Antibody |
| Immunogen |
CatNo: Eg2980 Product name: Recombinant Human CD21 protein (rFc Tag) Source: mammalian cells-derived, V37 Tag: C-rFc Domain: 21-971 aa of NM_001877.5 Sequence: ISCGSPPPILNGRISYYSTPIAVGTVIRYSCSGTFRLIGEKSLLCITKDKVDGTWDKPAPKCEYFNKYSSCPEPIVPGGYKIRGSTPYRHGDSVTFACKTNFSMNGNKSVWCQANNMWGPTRLPTCVSVFPLECPALPMIHNGHHTSENVGSIAPGLSVTYSCESGYLLVGEKIINCLSSGKWSAVPPTCEEARCKSLGRFPNGKVKEPPILRVGVTANFFCDEGYRLQGPPSSRCVIAGQGVAWTKMPVCEEIFCPSPPPILNGRHIGNSLANVSYGSIVTYTCDPDPEEGVNFILIGESTLRCTVDSQKTGTWSGPAPRCELSTSAVQCPHPQILRGRMVSGQKDRYTYNDTVIFACMFGFTLKGSKQIRCNAQGTWEPSAPVCEKECQAPPNILNGQKEDRHMVRFDPGTSIKYSCNPGYVLVGEESIQCTSEGVWTPPVPQCKVAACEATGRQLLTKPQHQFVRPDVNSSCGEGYKLSGSVYQECQGTIPWFMEIRLCKEITCPPPPVIYNGAHTGSSLEDFPYGTTVTYTCNPGPERGVEFSLIGESTIRCTSNDQERGTWSGPAPLCKLSLLAVQCSHVHIANGYKISGKEAPYFYNDTVTFKCYSGFTLKGSSQIRCKADNTWDPEIPVCEKETCQHVRQSLQELPAGSRVELVNTSCQDGYQLTGHAYQMCQDAENGIWFKKIPLCKVIHCHPPPVIVNGKHTGMMAENFLYGNEVSYECDQGFYLLGEKKLQCRSDSKGHGSWSGPSPQCLRSPPVTRCPNPEVKHGYKLNKTHSAYSHNDIVYVDCNPGFIMNGSRVIRCHTDNTWVPGVPTCIKKAFIGCPPPPKTPNGNHTGGNIARFSPGMSILYSCDQGYLLVGEALLLCTHEGTWSQPAPHCKEVNCSSPADMDGIQKGLEPRKMYQYGAVVTLECEDGYMLEGSPQSQCQSDHQWNPPLAVCRSR 相同性解析による交差性が予測される生物種 |
| Full Name | complement component (3d/Epstein Barr virus) receptor 2 |
| Calculated molecular weight | 113 kDa |
| Observed molecular weight | 150 kDa |
| GenBank accession number | NM_001877.5 |
| Gene Symbol | CD21 |
| Gene ID (NCBI) | 1380 |
| ENSEMBL Gene ID | ENSG00000117322 |
| Conjugate | Unconjugated |
| Form | |
| Form | Liquid |
| Purification Method | Protein A purification |
| UNIPROT ID | P20023-1 |
| Storage Buffer | PBS only{{ptg:BufferTemp}}7.3 |
| Storage Conditions | Store at -80°C. |
Background Information
CD21, also known as complement receptor type 2 (CR2), complement C3d receptor, and Epstein-Barr virus receptor, is a transmembrane protein that contains a small cytoplasmic domain, a transmembrane region and an extracellular domain consisting of 15 tandem short consensus repeat sequences (PMID: 6230668; 2551147). It is expressed on B cells, follicular dendritic cells, thymocytes and a subset of peripheral T cells (PMID: 26119182). CD21 binds complement fragments C3d, C3dg and iC3b and acts as a receptor for the Epstein-Barr virus (PMID: 7753047). On B cells, together with CD19 and CD81, CD21 forms a complex that functions as a co-receptor to the BCR (PMID: 7542009). It is involved in B cells activation and functions.